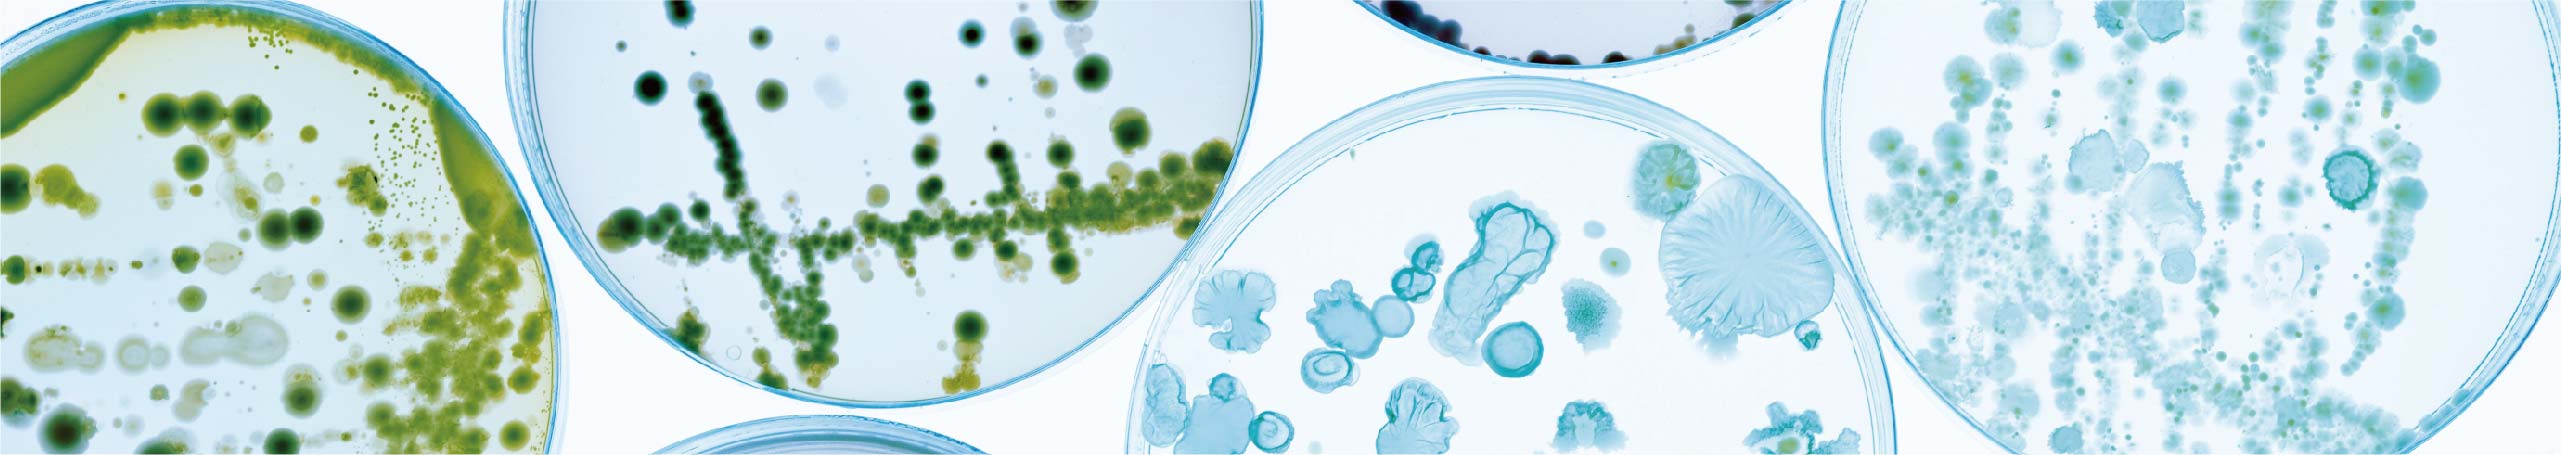

????? ??????? ????????
????? ????? ????? ?????? ????? ??????
????? ???????? ????? ?????? ??????? ???????? ??????? ?????????? ???? ???? Angel ??? ????? ?????? ????? ??????? ??????? ??? ?????? ?????? ?? ???? ????? ??????? ?? ???? ????? ?????? ????? ??????? ?????? ???????.
| ????? | ???????? | ????????? | ?????? |
| ?????? ??????? | ????? ???? | ??????? ?????? ???? | ? ??? ?????????? ???? ????? ??? ???? |
| ? ????? ????? ????? | |||
| ??? ????? | ????? ????? ??????? | ? ????? ????? ???????? ???? ???????? | |
| ????????? ???????? | ??? ??????? | ????? ??????? | ? ??????? ????????? |
| ? ???? ?????? ?????? ??????? | |||
| ? ????? ?????? | |||
| LB ????? | ????? ????????? ????????? | ? ?????? ??????? ??????? ??? ???? ???? ?? ????? ??????? | |
| ???????? ????? ??????? ?? ????????? | |||
| ??? ???? | ??????? ????????? | ? ????? ??????? ?? ???????? ?????? ?????? | |
| ? ????? ????? ????? | |||
| ? ????? ????? | |||
| ??? | ??? ?????? ???????? | ????? ?????? | ? ??? ???????? ???????? |
| ? ???? ??????? ??????? ???????? ????? ??????? ???? ???? ????? | |||
| ??? ??????? | ? ???? ????????? | ||
| ? ??? ????? ????? ??????? ??????? ????? |
????? ??? ???




